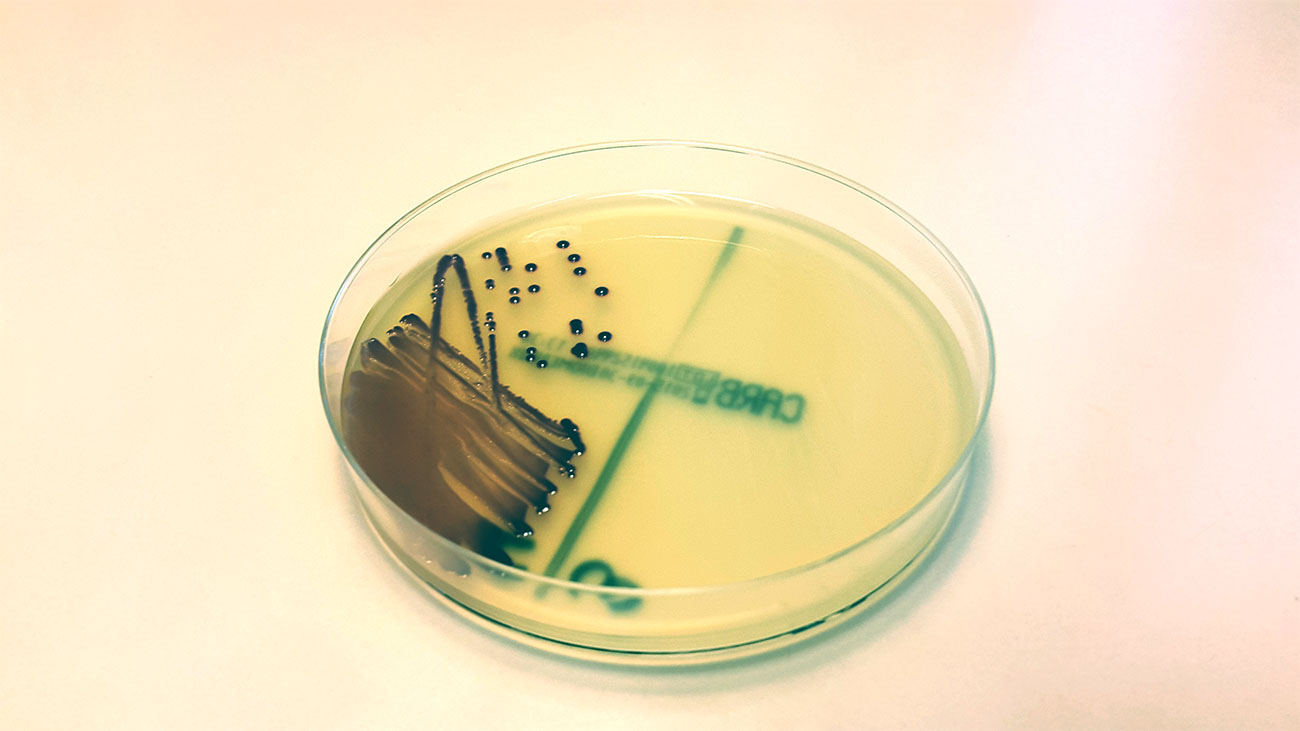

Övervakning bidrar till minskad antibiotikaresistens
Under Internationella antibiotikaveckan 18–24 november uppmärksammar SVA utmaningen med antibiotikaresistens. I Sverige är förbrukningen av antibiotika låg och resistensläget gott i ett internationellt perspektiv, tack vare ett bra förebyggande arbete och klok användning av läkemedel.
En annan viktig faktor är SVA:s övervakning, som behöver få in fler prover för att öka chansen att upptäcka problem.
För en beredskapsmyndighet som SVA är antibiotikaresistens en prioriterad fråga. Strategiskt arbete kring antibiotika kräver kunskap om resistensläget och hur mycket antibiotika som används. Därför övervakas det kontinuerligt sedan år 2000 av SVA, vilket ger ett underlag för genomtänkta antibiotikaval.
SVA behöver framförallt fler prover för sjukdomsframkallande bakterier från livsmedelsproducerande djur. Antalet prover är lågt jämfört med provunderlaget från hund, katt och häst.
– Ett större antal prover skulle öka chansen för oss att tidigt kunna upptäcka eventuella problem. Det skulle också göra oss mer trygga i våra bedömningar av läget, säger Oskar Nilsson, chef vid sektionen för antibiotikafrågor.
Fler prover ger bättre data
Det kan finnas flera skäl till att provunderlaget är otillräckligt. Vissa sjukdomar finns sällan i Sverige, och för andra görs det inte alltid undersökningar som ger SVA rätt typ av underlag. Dessutom inkluderas bara analyser från SVA i övervakningen.
– Jag hoppas att alla som berörs funderar på vilken insats de kan göra. Får vi in fler prover kan både vi, djurägarna och veterinärerna få ut mer användbar information. Och vi på SVA behöver skapa fler samarbeten med andra laboratorier, som kan ge oss kvalitetssäkrade resistensdata, säger Oskar Nilsson.
Veterinärer och djurägare är centrala
Arbetet mot antibiotikaresistens måste vara långsiktigt, och många olika aktörer behöver samverka. Grunden är att förebygga sjukdom och minska spridning av resistens. Idag har den stora majoriteten av djurslag i Sverige ett gott resistensläge.
Bra djurhälsa är nyckeln till framgång
– Vi är tacksamma till alla veterinärer och djurägare i Sverige som ser det som en viktig fråga och tar sin roll i det här arbetet på allvar. Vårt målmedvetna arbete med att hålla djuren friska minskar behovet av antibiotika, och när det väl används väljer veterinärer och djurägare oftast läkemedel med minsta möjliga påverkan på resistensläget, säger Oskar Nilsson.
Penicillin är vanligast
Bakterier som orsakar sjukdom hos djur är vanligtvis känsliga för de antibiotika som används vid behandling. Oftast används penicillin, ett smalspektrigt antibiotikum som innebär mindre påverkan på resistensen.
– Som djurägare är det till exempel viktigt att följa veterinärens råd, lämna in överblivna läkemedel på apotek, och se till att djuret är vaccinerat. Det gör att användningen av antibiotika fortsatt kan hållas på en låg nivå, säger Oskar Nilsson.